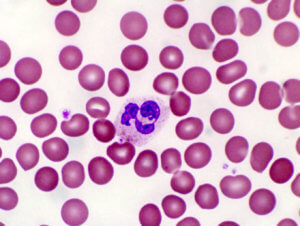
image

Содержание
Как известно, кровь является разновидностью соединительной ткани и имеет жидкую консистенцию. Она свободно циркулирует по замкнутой сети кровеносных сосудов, перемещая тем самым питательные вещества и кислород к клеткам тела, а непереваренные остатки и углекислый газ из них. В составе крови выделяют жидкую часть – плазму и форменные элементы – клетки крови.
Клеточных элементов в крови выделяется около трех групп: эритроциты, лейкоциты и тромбоциты. Именно от содержания и состояния клеточных элементов и зависит состояние организма человека и его общее самочувствие. Изменение состава клеток крови служит сигналом к развитию у человека, каких либо изменений в организме, связанных с проникновением в него чужеродных элементов либо заболеваний.
Одним из показателей анализа крови являются нейтрофилы, их обозначают латинскими буквами NEU. Рассмотрим подробнее, какова их норма и о чем свидетельствует отклонение
Значение общего анализа крови

Анализ крови проводится в лабораторных условиях с задействованием специального оборудования, позволяющего получить результат в течение двадцати четырех часов. Опытные специалисты лабораторий производят данную процедуру быстро и безопасно для организма.
Благодаря такой процедуре у человека можно выявить развитие любых даже незначительных отклонений уже на ранних стадиях их появление. Следствием чего будет назначено комплексное и эффективное лечение.
Общий анализ крови, может с точностью определить физические, биологические и химические характеристики кровяной среды.
Именно по этим показателям врачи и определяют состояние здоровья человека. Сдача крови на анализ является наиболее распространенной методикой обследования, помогающей выявить причины развития в организме многих заболеваний. Такой анализ крови позволяет и определить факторы вызывающие у человека головокружение, проявления слабости, а также резкое повышение температуры.
В большинстве случаев, анализ крови производят по составу капиллярной крови, которую берут из сосудов любого пальца руки или извлекая кровяную ткань непосредственно из вены. Для того чтобы сдать такой анализ не требуется особой подготовки, кроме случаев, когда сдача крови проводится натощак. Перед сдачей такого анализа не рекомендуется употреблять и спиртные напитки.
О чем “говорит” анализ крови?

При выяснении анализы крови врачи одним из первых определяют количество гемоглобина в ней. Как известно гемоглобин входит в состав эритроцитов и отвечает за перемещение кислорода по организму.
Чем меньше гемоглобина, тем хуже себя чувствует человек, так как происходит уменьшение доставляемого кислорода к тканям. В нормальном состоянии количество гемоглобина у мужчин от ста двадцати до ста шестидесяти, а у женщин несколько меньше, до ста сорока на единицу измерения.
Понижение гемоглобина служит сигналом к развитию у человека анемии, заболевания связанного с нехваткой данного элемента в крови.
Превышение допустимой нормы содержания гемоглобина свидетельствует о эритремии, заболевание хронического лейкоза на клеточном уровне.
Кроме количества гемоглобина, врачи исследуют содержание в крови тромбоцитов:
- Как известно, эти кровяные пластинки ответственны за процесс свертывания крови в организме.
- В нормальном содержание тромбоциты исчисляются в диапазоне от ста семидесяти до трехсот двадцати на кровяной литр.
- Тромбоциты отвечают и за подбор на мембранных стенках сосудов противовоспалительных элементов.
- У человека с пониженных содержанием тромбоцитов в организме наблюдается некий разлад и повреждения. К тому же уменьшение количества кровяных пластинок сигнализирует о иммунологическом нарушении или начавшемся в организме воспалительном процессе.
Полезное видео о том, как правильно подготовиться к анализу крови:
Количество лейкоцитов также можно обнаружить по исследованиям сданной человеком крови. Лейкоциты служат главными борцами организма с проникающими в него инфекциями.
В норме у пациента на литр кровяной ткани насчитывается число лейкоцитов в количестве (3-8)*109. Повышенное количество лейкоцитов свидетельствует о развитии в организме какой-либо инфекции, наиболее частым заболеванием от такого содержания является лейкоз.
Снижение уровня лейкоцитов в крови также является сигналом попадания в организм инфекции, угнетающей процесс выработки данных кровяных клеток через костный мозг.
Причиной снижения числа лейкоцитов в крови является и развитие у человека онкологических заболеваний, истощение организма или аутоиммунных болезней.
Все эти три группы клеток крови очень важны и должны находиться у человека на стабильном уровне. Только сдача анализа крови позволит выяснить количество данных элементов в ее составе.
NEU в анализе – что это за показатель?

В здоровом теле число нейтрофилов определяется в процентном содержании равном семидесяти, от общего количества всех лейкоцитов. Местонахождение нейтрофилов обозначается на слизистых поверхностях оболочек клеток, а также под ними.
Главное предназначение этих элементов заключается в пожирании микроорганизмов чужеродной природы, проникающих в организм. При этом зачастую наблюдается образования гноя, за счет скопления нейтрофилов. Воспаление при такой ситуации имеет место быть.
В случаях, когда идет гнойный процесс, но не происходит существенного увеличения числа нейтрофилов, пациенту следует насторожиться. Такой признак служит сигналом развития в организме иммунодефицита.
По своему строению нейтрофилы подразделяются на:
- Нейтрофильные лейкоциты
- Нейтрофильные гранулоциты
- Сегментоядерные нейтрофилы
Все эти подвиды нейтрофилов встречаются в теле человека и каждая группа ответственна за выполнение определенной функции. Гранулоцитарные лейкоциты – большая группа лейкоцитов, включающих в себя данные подвиды.
Нейтрофилы получили свое название за свое окрашивание.
По методике Романовского окрашивание нейтрофилов осуществляется при помощи кислого красителя, которые называется эозин, а также применяя основной краситель. И в первом и во втором случае нейтрофилы окрашиваются в отличии других элементов крови. Окрашивание элементов помогает лучше разглядеть их в микроскоп и изучить их структуру.
В норме нейтрофилы имеют мелковатую структуру с пылевидной зернистостью и окрашены в розовато-фиолетовый цвет. Значение данных частиц очень велико для работоспособности организма, особенно при попадании в него инфекционных агентов. Поэтому человеку при необходимости назначают сдачу крови на Neu анализ.
Нейтрофилы и их значение
Нейтрофилы ответственны за предупреждение в организме воспалительных процессов. При развитии у человека воспаления, нейтрофилы начинают активное движение к месту очага воспалительного процесса. На своем движении они выделяют особые гидролитические ферменты, а также вещества, относящиеся к группе пероксидаз. Эти вещества оказывают на организм сильное бактерицидное действие.
В основном главными противниками, против которых борются нейтрофилы, являются бактериальные инфекции, которых в природе очень много.
В структурном содержании нейтрофилы имеют специфические механизмы, позволяющие распознавать природу попавшего в организм возбудителя заболевания. На основе этого свойства нейтрофилы и способны избирательно уничтожать своего противника и обеспечивать наибыстрейшее выздоровление организму.
Нейтрофилез
Под нейтрофилезом понимается увеличение числа нейтрофилов. Это свойство является усилением защиты организма, если на него из окружающей среды действуют различные факторы эндогенной или экзогенной природы.
Больше информации о нейтрофилах можно узнать из видео:
Нейтрофилез может быть вызван действием следующих факторов:
- Инфекционное воздействие (проникновение в организм грибков, бактерий или паразитов).
- Воспалительные процессы (развитие в организме холецистита, сепсиса, панкреатита, аппендицита, абсцедирующей пневмонии, перитонита, плеврита, васкулита, миокардита, перикардита, артрита или миозита).
- Развитие у человека болезней, сопровождающихся некрозами, или повреждением с распадом тканей (панкреонекроз, инфаркт миокарда, гангрена, трофические язвочки, ожоговые поражения).
- Различные виды интоксикаций (печеночной комы, уремии).
- Воздействие лекарственных препаратов (введение белка, попадание бензола в организм, прием кортикостероидов, применение гистаминных средств, отравления свинцом);
- Открытие острых течений крови.
- Приступы связанные с гемолитическим кризом.
- Образование злокачественных опухолевых уплотнений (в желудке, на бронхах и поджелудочной железе, в нервной системе).
- Заболевания, поражающие кровь (развитие эритремии, появление острого или хронического миелолейкоза, возникновение миелофиброза).
Все эти факторы вызывают увеличение числа нейтрофилов в крови. Наиболее часто нейтрофилез сочетается с лейкоцитозом.
Нейтропения

Она может быть вызвана влиянием на организм следующих факторов:
- Проникновение в тело инфекций. Вирусная природа (развитие гриппа или кори, появление краснухи или ветряной оспы, распространение у человека инфекционного гепатита или СПИДа). Бактериальная природа (поражение брюшным тифом).
- Развитие у человека инфекционных или воспалительных заболеваний, сопровождающихся возникновением генерализованных инфекций.
- Побочное действие от приема лекарственных средств (применение противосудорожных или цитостатических средств, прием сульфаниламидов, анальгетиков или антитиреоидных препаратов).
- Применение лучевой терапии или ионизирующего облучения.
- Развитие гиперспленизма, сопровождающегося увеличением селезенки.
- Гипоанемия.
- Анафилактический шок.
- Апластическая анемия.
- Агранулоцитоз.
В диагностике значимо выявление дегенеративных видов нейтрофилов, которые могут присутствовать в крови. Так, если в организм попадает инфекционный агент, цитоплазма клеток может содержать крупные гранулы, окрашенные базофильно.
Гиперсегментированные нейтрофилы, могут присутствовать в составе крови при развитии у человека фолиеводефицитной анемии или различных типов лейкоза.
Многие инфекции и гнойно-воспалительные заболевания также служат источниками появления в организме гиперсегментированных нейтрофилов.
Заметили ошибку? Выделите ее и нажмите Ctrl+Enter, чтобы сообщить нам.









